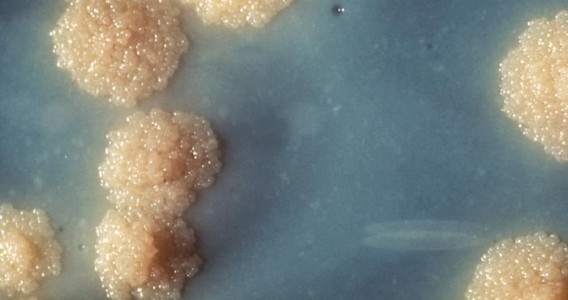
Nanopartícula com ferro elimina tuberculose em camundongos e pode abrir caminho para novos tratamentos

Novo centro de pesquisa usará relógios e anéis inteligentes para detecção precoce de doenças
Criado por FAPESP, Unicamp e Samsung, o Viva Bem desenvolverá algoritmos e tecnologias de IA embarcadas nesses dispositivos para detectar sinais de Parkinson e outras condições antes mesmo do surgimento dos sintomas
Uso de suplemento antes de cirurgia melhora regeneração do fígado
Experimento com camundongos feito na Unicamp testou a ação do HMB, um derivado do aminoácido leucina já usado na preservação da massa muscular
Árvores gigantes de florestas tropicais superam limites físicos para transportar água até o topo
Estudo publicado na Science mostra que espécies com altura equivalente à de prédios de 30 andares desenvolveram adaptações internas e – ao contrário do que se pensava – não são mais vulneráveis a secas do que a vegetação mais baixa

86% das crianças com dor incapacitante nos ossos, músculos ou ligamentos se recuperam
Pesquisa acompanhou 694 jovens por 18 meses e constatou que, embora a maioria supere o problema no período, taxa de recorrência chega a 32%. Negligenciar a queixa eleva o risco de dores crônicas na vida adulta, alertam especialistas
IPT celebra 127 anos e homenageia instituições parceiras
Em cerimônia, entidades como FAPESP, Finep e USP foram reconhecidas pelo apoio à ciência aplicada
Avanço de árvores no Cerrado causa a morte de plantas rasteiras por inanição
Estudo mostra que as gramíneas e ervas não desaparecem por simples intolerância à sombra, mas sim porque a falta de luz faz com que esgotem suas reservas subterrâneas de energia
FAPESP, Unicamp e Funcamp assinam convênio de cooperação institucional
O documento estabelece diretrizes para a gestão administrativa e financeira das atividades de aquisição por importação de bens e contratação de serviços no exterior necessários à realização de pesquisas científicas
OPORTUNIDADES FAPESP
JC-2 em administração
FEA-USP
Inscrições até 20/07/2026
PD em ciência da informação / ciência política / economia da inovação / diplomacia da ciência / comunicação científica
IG-Unicamp
Inscrições até 20/07/2026
TT-5 em genética molecular de Leishmania / bioinformática
FMRP-USP
Inscrições até 20/07/2026
PD em sistema de produção / ecofisiologia
Esalq-USP
Inscrições até 18/07/2026
TT-4 em educação
IEA-USP
Inscrições até 19/07/2026
PD em química de materiais
LNNano/CNPEM
Inscrições até 20/07/2026
Vídeos
Agricultura sustentável
Desenvolvimento de Fármacos
Agenda
Encontros do Grupo de Pesquisa sobre Física Nuclear e Partículas
29/05/2026 a 31/07/2026
Manifestações artísticas no enfrentamento à repressão
27/06/2026 a 28/03/2027
Imersão em Física para OBFEP/OBF e ONC
04/07/2026 a 01/08/2026
Jornada II – A perspectiva da complexidade para abordar questões socioambientais e riscos
06/07/2026 a 08/07/2026
9º Perimeter-SAIFR-IFT Journeys into Theoretical Physics
06/07/2026 a 12/07/2026
Webinário sobre bolsas de Iniciação Tecnológica
08/07/2026 a 08/07/2026
28º Encontro USP-Escola
13/07/2026 a 17/07/2026
18º Curso de Inverno de Temas Avançados em Bioquímica e Biologia Molecular
13/07/2026 a 17/07/2026
Chamadas FAPESP
Trans-Atlantic Platform
Fase de pré-propostas
Prazo: 08/07/2026
CONFAP / European Research Comission
Prazo: 10/07/2026
Auxílio à Inovação Regular - Iniciação Tecnológica
Prazo: 13/07/2026
Natural Environmental Research Council (UKRI)
Prazo: 16/07/2026
Pesquisa em Políticas Públicas
Fase Municipal
Prazo: 20/07/2026